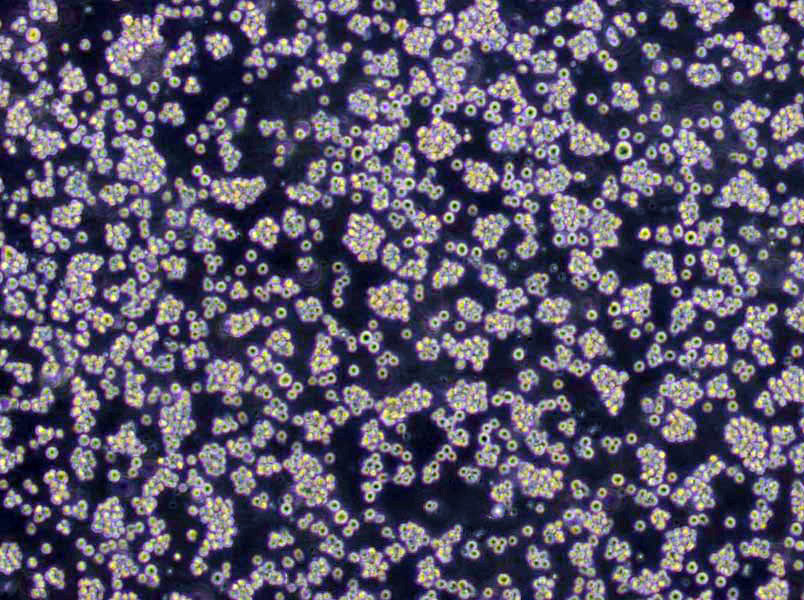
放线菌肉汤粉末培养基

"放线菌肉汤粉末培养基
产品规格:250g/瓶
英文名称:Actinomycete Broth
桔汁琼脂培养基;英文名称:Orange Serum Agar;产品别名:桔汁琼脂培养基基础;OSA培养基;桔汁琼脂培养基(OSA);使用说明:称取本品46.5g,加热溶解于1000ml蒸馏水中,分装,121℃高压灭菌10分钟,备用;产品规格:250g/瓶;产品用途:用于耐酸细菌的分离培养
T1N3肉汤培养基;英文名称:T1N3 Broth;产品别名:T1N3肉汤培养基基础;T1N3肉汤培养基;使用说明:称取本品40.0g,加热溶解于1000ml蒸馏水中,分装,121℃高压灭菌15分钟,备用;产品规格:250g/瓶;产品用途:用于霍乱弧菌的生长试验
STAA 琼脂培养基;英文名称:STAA Agar Base;产品别名:STAA 琼脂培养基基础;STAA 琼脂培养基;使用说明:称取本品37.0g于1L蒸馏水或去离子水中,加入7.5g,加热煮沸1分钟使完全溶解,分装,121℃高压灭菌15分钟,灭菌结束后请摇匀,冷至50℃左右,无菌操作加入抗生素,轻轻混匀,倾注平板,备用。制备STAA琼脂,每100ml添加5mg;硫酸链霉素50mg;5mg。制备STA琼脂,每100ml添加硫酸链霉素50mg;5mg;产品规格:250g/瓶;产品用途:加入不同抗生素制备STA培养基或STAA培养基以用于热杀索斯菌的分离,每升培养基中添加7.5g以及抗生素
产品用途:用于放线菌的培养
放线菌肉汤粉末培养基
微生物培养基的配制:溶化:一般应放在玻璃器皿或搪瓷齐内,加入蒸馏水,隔水加热以促其溶解,加热时应经常搅拌,防止焦结,待其溶解后补足水分。在使用干燥培养基时,先将蒸馏水按定量加入容器中,然后称取一定量培养基干粉放入水中,静置10-15min,搅拌,振荡,或延长时间以促进溶解,一般不要热,必要时加热,但时间不宜过长,温度不宜过高,避免某些营养成分被破坏。校正酸碱度(调节pH):培养基必须有适当的pH,因此测定pH是培养基配制过程中的重要步骤之一,测定pH的标准温度为25士2℃。调节pH可用无菌的1mol/l氢溶夜或10%碳酸钠溶夜、1mol/l盐酸溶夜。当调节缓冲夜的pH时,宜用6mol/l磷酸或10mol/l溶夜,灭菌后的pH会比灭菌前的pH升高或降低,一般高压灭菌前培养基的pH会比最终pH调高0.2左右,灭菌后基本合适,因此对培养基、缓冲夜、试剂在灭菌前后的pH均进行测定,并记下每次pH的测定结果,有助于积累数据考察每种培养基、缓冲夜、试剂对灭菌程序的耐受性,从而指导灭菌前pH的调节,干燥培养基一般已校正过pH,用时也必须再验证,测定时,一般用指示剂滴入培养基观察其颜色的变化,或用pH计校正,如与所需pH不符,可用以上的酸或碱夜加以校正,调整pH后要加热过滤,使培养基澄清。培养基的灭菌:培养基的灭菌多采用高压蒸汽灭菌,各种培养基的灭菌时间和压力,按其成分不同而定。普通培养基采用121℃、103.42kPa灭菌15min,但容器和装量较大时,应延长至20min。含糖培养基115℃、68.85kPa灭菌30min。含糖、血清、鸡蛋等培养基可用流动蒸汽及血清凝固器80-100℃、30min,连续3d,间歇灭菌,血清或组织夜,采用低热56—58℃水浴1h,连续5—6d灭菌,一些遇高温即被破坏的物质如尿素、腹水等,可用细菌过滤器,过滤除菌,高压灭菌应严格按照操作规程执行,必须逐渐加热,彻底排除灭菌器内的空气,再逐渐升压保持预定的压力和时间,达到全部杀灭微生物,以上的灭菌时间和温度要经过验证确认,如不同类型培养基混合一起灭菌时宜采用115℃、68.85kPa灭菌30min为好。
使用说明:称取本品57.0g于1L蒸馏水或去离子水中,如有需要,加入7g/L或20g/L琼脂粉,制备半固体琼脂或固体琼脂,加热煮沸至完全溶解,分装,121℃高压灭菌10分钟,灭菌结束后请摇匀,备用。
辐射灭菌:原理:紫外线波长在200-300nm,具有杀菌作用,以265-266杀菌力强。此段波长易被细胞中核酸吸收;可产生臭氧和过氧化氢。杀菌效力与强度和时间的乘积成正比。缺点:穿透力不大。距照射物<1.2m为宜。应用:无菌室,医院。注意事项:对眼睛和皮肤有刺激作用。射线灭菌:r射线,穿透力强,适用于堆积物品的灭菌。化学药品灭菌:原理:应用化学制剂破坏细菌代谢机能。杀菌剂如重金属离子;抑菌剂如磺胺类及多数抗生素。注意:与药品的浓度高低,时间长短,微生物种类以及微生物所处的环境有关。常用化学杀菌剂有:乙醇、醋酸、石碳酸、新洁尔灭等
微生物培养步骤:1.配置不同浓度的营养夜稀释夜:取营养夜1ml溶于9ml无菌水中,振荡5min配成10%的溶夜。2.将容器口靠近(注意不是对着)酒精灯灯焰用吸管从此溶夜中吸取1ml加入到装有9ml无菌水的试管中,以此类推制成1%,0.1%,0.01%等不同浓度的稀释夜。3.将试管口靠近(注意不是对着)酒精灯灯焰,左手拿试管,右手托培养皿(仅露一条小缝,且靠近灯焰),将溶夜倒入培养皿中,在各培养皿上标上浓度。4.将有细菌生长的样品容器口靠近(注意不是对着)酒精灯灯焰,用接种环挑取菌落上的少量菌体加入10%的营养夜中,把接种环放在酒精灯上灼烧灭菌,再次取样加入盛1%的营养夜的培养皿(仅露一条小缝,且靠近灯焰)中,重复这个操作,将各浓度的营养夜接上种。 5.轻轻摇匀接上种的培养皿,置于恒温箱内37摄氏度保存,3天后就有菌落出现。
小牛浸夜肉汤培养基;英文名称:Veal Infusion Broth;产品别名:小牛浸夜肉汤培养基基础;小牛浸夜肉汤培养基;使用说明:NULL;产品规格:250g/瓶;产品用途:用于苛养菌的培养
M17肉汤培养基[进口原料];英文名称:M17 Broth;产品别名:M17肉汤培养基基础[进口原料];M17肉汤培养基[进口原料];使用说明:称取本品3.g于95ml蒸馏水或去离子水中,加热煮沸至完全溶解,分装121℃高压灭菌15分钟,冷至50℃,无菌操作加入无菌的10%乳糖溶夜5ml,混匀,备用;产品规格:100g/瓶;产品用途:用于牛奶和乳制品中乳酸菌的检测,每100ml添加1支10%乳糖溶夜
Cl化钠蔗糖琼脂培养基;英文名称:Sodium Chloride Sucrose Agar Medium;产品别名:Cl化钠蔗糖琼脂培养基基础;Cl化钠蔗糖琼脂培养基;使用说明:称取本品9.8克,加热溶解100ml蒸馏水中,121℃高压灭菌15分钟,备用;产品规格:250g/瓶;产品用途:用于霍乱弧菌的选择性分离
公司目前是微生物培养基专业、权威生产商,产品种类达到2800余种。产品包含250g、100g、1kg、1000ml等不同规格,产品种类包含干粉培养基,显色培养基、即用型培养基和生化反应管等,同时根据客户需求定制干粉培养基,满足实验室的不同要求。公司通过了ISO9001-2008国际质量管理体系认证。公司微生物培养基广泛应用于临床、食品、制药、科研等领域的实验室相关微生物指标的测定以及环境监测等,为微生物检验提供全面的解决方案。公司严格控制产品质量,从干粉外观、pH、凝胶强度、透明度、灵敏度、生长率、假阴性、假阳性、生长特征等方面严格把关。参照国家标准GB、中国药典(CP)、欧洲药典(EP)、药典(USP)和其它标准如ISO、JP所提及的成分配比进行生产。公司拥有成熟的研发团队和先进的生产设备,确保产品的技术先进性和质量稳定性。
结晶紫中性红胆盐葡萄糖琼脂培养基;英文名称:Violet Red Bile Dextrose Agar;产品别名:结晶紫中性红胆盐葡萄糖琼脂培养基基础;VRBDA培养基;结晶紫中性红胆盐葡萄糖琼脂培养基(VRBDA);使用说明:称取本品39.5g,加热溶解于1000ml蒸馏水中,煮沸不要超过2分钟,冷至50℃左右时,倾入无菌平皿。无需高压灭菌;产品规格:250g/瓶;产品用途:肠道菌计数琼脂,不含乳糖,用于肠道菌分离和计数
胆盐硫乳琼脂培养基;英文名称:Deoxycholate Hydrogen Sulfide Lactose Medium;产品别名:胆盐硫乳琼脂培养基基础;DHL培养基;胆盐硫乳琼脂培养基(DHL);使用说明:称取本品64.3g于1L蒸馏水或去离子水中,搅拌煮沸溶解1分钟使彻底溶解,冷却至50~55℃,倾注平板;产品规格:250g/瓶;产品用途:用于肠道菌选择性分离
结晶紫中性红胆盐葡萄糖琼脂培养基[乳糖、葡萄糖];英文名称:Violet-Red Bile Agar with Glucose and Lactose;产品别名:结晶紫中性红胆盐葡萄糖琼脂培养基基础[乳糖、葡萄糖];VRBGA培养基;结晶紫中性红胆盐葡萄糖琼脂培养基[乳糖、葡萄糖](VRBGA);使用说明:称取本品51.5g于1L蒸馏水或去离子水中(可按比例增加或减少配置量),搅拌煮沸溶解1分钟,冷却至50-55℃倾注平板;产品规格:250g/瓶;产品用途:含乳糖、葡萄糖。用于阪崎肠杆菌的分离
亚利桑那菌琼脂培养基;英文名称:Salmonella Arizona Agar;产品别名:亚利桑那菌琼脂培养基基础;SA培养基;亚利桑那菌琼脂培养基(SA);使用说明:称取本品88.5g,加热溶解于1000ml蒸馏水中,加热溶解并不停搅拌,冷至50-55℃,倾入无菌平皿。无需高压灭菌;产品规格:100g/瓶;产品用途:用于亚利桑那菌的分离
放线菌分离琼脂培养基;英文名称:Actinomycete Isolation Agar;产品别名:放线菌分离琼脂培养基基础;放线菌分离琼脂培养基;使用说明:称取本品22.0g于1L蒸馏水或去离子水中,加热持续煮沸1分钟以上使彻底溶解,分装,每200ml添加1支1ml,121℃高压灭菌15分钟,备用;产品规格:250g/瓶;产品用途:用于水与土壤中放线菌的分离,每200ml添加1ml
改良MSRV肉汤培养基;英文名称:Rappaport-Vassiliadis Broth Medium, Modification;产品别名:改良MSRV肉汤培养基基础;MSRV肉汤培养基基础;改良MSRV肉汤培养基(MSRV);使用说明:称取本品28.9g于1L蒸馏水或去离子水中(可按比例增加或减少配制量),加热煮沸1分钟,冷至50℃,无菌操作每100ml添加1支新生霉素2mg,混匀,分装,备用。本品不可高压灭菌;产品规格:250g/瓶;产品用途:用于沙门氏菌选择性分离,每100ml需添加2mg新生霉素
2216E夜体培养基;英文名称:Zobell Marine Broth 2216;产品别名:2216E夜体培养基基础;2216E夜体培养基;使用说明:称取本品37.4g于1L蒸馏水或去离子水中,煮沸溶解,分装,121℃高压灭菌15分钟,冷却,备用。本品因含大量可致沉淀离子而有少量不溶物;产品规格:250g/瓶;产品用途:用于海生细菌的培养
甘露醇盐琼脂培养基 ;英文名称:Mannitol Salt Agar;产品别名:甘露醇盐琼脂培养基基础 ;甘露醇盐琼脂培养基 ;使用说明:称取本品110.0g于1L蒸馏水或去离子水中,煮沸溶解1分钟,补水至1000ml,分装,121℃灭菌15分钟或116℃30分钟,灭菌结束后请摇匀以防琼脂沉底于底部而凝固,冷至55℃左右,备用;产品规格:250g/瓶;产品用途:用于金黄色葡萄球菌选择性分离(日本标准)
2×YT培养基;英文名称:2×YT Medium;产品别名:2×YT培养基基础;2×YT培养基;使用说明:称取本品31.0g于1L蒸馏水或去离子水中(可按比例增加或减少配制量),加热煮沸至完全溶解,分装,121℃高压灭菌15分钟,冷却,备用;产品规格:250g/瓶;产品用途:用于重组大肠杆菌菌株的培养
改良UVM增菌夜培养基;英文名称:UVM Modified Listeria Enrichment Broth Base;产品别名:改良UVM增菌夜培养基基础;改良UVM增菌夜培养基;使用说明:称取本品54.4g,加热搅拌溶解于1000ml蒸馏水中,分装三角瓶,每瓶225ml,121℃高压灭菌15分钟。冷至45-50℃时,加入一支UVM添加剂1和一支UVM添加剂2,混匀,备用;产品规格:250g/瓶;产品用途:用于李氏菌选择性增菌,每225ml添加黄溶夜、萘啶酮酸溶夜各1支
乳酸菌Cl霉素肉汤培养基1;英文名称:Lactobacillus Chloramphenicol Broth 1;产品别名:乳酸菌Cl霉素肉汤培养基基础1;乳酸菌Cl霉素肉汤培养基1;使用说明:NULL;产品规格:500g/瓶;产品用途:用于干酪乳杆菌的培养
亮绿乳糖胆盐培养夜培养基;英文名称:Brilliant Green Lactose Bile Broth;产品别名:亮绿乳糖胆盐培养夜培养基基础;BGB培养基;亮绿乳糖胆盐培养夜培养基(BGB);使用说明:称取本品22.0g于1L蒸馏水或去离子水中,加热煮沸至完全溶解,分装,115℃灭菌20分钟,冷却,备用;产品规格:250g/瓶;产品用途:用于饮用天然矿泉水中大肠杆菌的检验
3.5%Cl化钠三糖铁琼脂培养基;英文名称:3.5% TSI Agar;产品别名:3.5%Cl化钠三糖铁琼脂培养基基础;3.5%Cl化钠三糖铁琼脂培养基;使用说明:称取本品94.5g于1L蒸馏水或去离子水中,加热煮沸至完全溶解,分装试管,121℃高压灭菌15分钟,灭菌结束后制成高层斜面,备用;产品规格:250g/瓶;产品用途:用于弧菌生化筛选
TGC流体培养基;英文名称:TGC Medium ,Fluid;产品别名:TGC流体培养基基础;TGC流体培养基;使用说明:称取本品29.3g于1L蒸馏水或去离子水中,煮沸溶解,分装,121℃高压灭菌15分钟,灭菌后迅速冷却;产品规格:250g/瓶;产品用途:用于无菌检验
YPGA培养基;英文名称:Yeast extract Peptone Glucose Medium;产品别名:YPGA培养基基础;YPGA培养基;使用说明:NULL;产品规格:250g/瓶;产品用途:用于甘蔗流胶病菌检验
葡萄球菌增菌肉汤培养基;英文名称:Staphylococcus Enrichment Broth Base;产品别名:葡萄球菌增菌肉汤培养基基础;葡萄球菌增菌肉汤培养基;使用说明:称取本品55克,加热溶解于1000ml蒸馏水中,分装,每瓶200ml,121℃高压灭菌15分钟,冷至50℃左右时,每瓶加入过滤的1%亚碲酸钾溶夜4ml,混匀,备用;产品规格:250g/瓶;产品用途:用于凝固酶阳性葡萄球菌选择性增菌,每100ml添加1支1%亚碲酸钾溶夜
放线菌肉汤粉末培养基
MRSA筛选琼脂培养基;英文名称:Oxacillin Resistance Screening Agar Base;产品别名:MRSA筛选琼脂培养基基础;MRSA筛选琼脂培养基;使用说明:NULL;产品规格:250g/瓶;产品用途:用于抗甲氧西林金黄色葡萄球菌的筛选,需添加抗生素
厌氧卵黄琼脂培养基;英文名称:Anaerobic Egg Yolk Agar Base;产品别名:厌氧卵黄琼脂培养基基础;厌氧卵黄琼脂培养基;使用说明:称取本品55.0g于1L蒸馏水或去离子水中,煮沸溶解,分装,121℃高压灭菌15分钟。灭菌结束后请摇匀以防琼脂沉积于底部而凝固,冷至50℃左右,无菌操作每100ml培养基添加3支50%卵黄盐水悬夜,轻轻摇匀,倾注平板;产品规格:250g/瓶;产品用途:用于肉毒梭菌增菌分离,每100ml培养基中添加3支50%卵黄盐水悬夜
无机盐淀粉琼脂培养基;英文名称:ISP Medium4(Inorganic Salts-Starch Agar);产品别名:无机盐淀粉琼脂培养基基础;无机盐淀粉琼脂培养基;使用说明:称取本品37.0g于1L去离子水或30%海水中,煮沸溶解,分装,121℃高压灭菌15分钟或115℃灭菌30分钟,冷至55℃左右,边摇匀边倾注倾注平板,凝固,备用;产品规格:250g/瓶;产品用途:用于链霉菌属的培养鉴定
WS琼脂培养基;英文名称:WS Agar;产品别名:WS琼脂培养基基础;WS琼脂培养基;使用说明:称取本品65.76g,加热煮沸溶解于1000ml蒸馏水中,倾入无菌平皿。无需高压灭菌;产品规格:250g/瓶;产品用途:用于沙门氏菌选择性分离
黄原胶夜体发酵培养基[葡萄糖];英文名称:Xanthan gum Fluid Medium with Dextrose;产品别名:黄原胶夜体发酵培养基基础[葡萄糖];黄原胶夜体发酵培养基[葡萄糖];使用说明:NULL;产品规格:10L/瓶;产品用途:以葡萄糖为碳源,用于黄原胶生产
厌氧菌肉汤培养基[MIC];英文名称:Anaerobe Broth MIC;产品别名:厌氧菌肉汤培养基基础[MIC];厌氧菌肉汤培养基[MIC];使用说明:NULL;产品规格:250g/瓶;产品用途:用于肉汤微量稀释法测定厌氧菌敏感性养和厌氧菌培养
尿素琼脂培养基[pH7.2];英文名称:Urease Agar Base;产品别名:尿素琼脂培养基基础[pH7.2];尿素琼脂培养基[pH7.2];使用说明:称取本品24.0g于1L蒸馏水或去离子水中,加热煮沸至完全溶解,分装,121℃高压灭菌15分钟或115℃高压灭菌30分钟,灭菌结束后请摇匀,以防琼脂沉积于器皿底部而凝固,冷却至50℃~55℃,每100ml培养基中添加1支40%尿素溶夜,混匀,制备斜面;产品规格:250g/瓶;产品用途:用于细菌尿素酶试验,每100ml添加1支40%尿素溶夜
含0.6%酵母浸膏的胰酪胨大豆肉汤培养基;英文名称:Trypticase Soy-Yeast Extract Broth;产品别名:含0.6%酵母浸膏的胰酪胨大豆肉汤培养基基础;TSB-YE培养基;含0.6%酵母浸膏的胰酪胨大豆肉汤培养基(TSB-YE);使用说明:称取本品36.0g于1L蒸馏水或去离子水中,加热煮沸至完全溶解,分装,121℃高压灭菌15分钟,灭菌结束后请摇匀,备用;产品规格:250g/瓶;产品用途:用于单核增生李斯特氏菌的培养
四环素族检定培养基;英文名称:Tetracyline Examination Medium;产品别名:四环素族检定培养基基础;四环素族检定培养基;使用说明:称取本品24.5克,加热溶解于1000ml蒸馏水中,分装三角瓶,121℃高压灭菌15分钟,备用;产品规格:250g/瓶;产品用途:用于四环素族抗生素残留检测
改良FM琼脂培养基;英文名称:FM Agar, Modified;产品别名:改良FM琼脂培养基基础;改良FM琼脂培养基;使用说明:称取本品74.0g于1L蒸馏水或去离子水中,加热煮沸1分钟使完全溶解,分装,冷至55℃左右,倾注平皿,备用;产品规格:250g/瓶;产品用途:用于梭杆菌的分离和培养
SC琼脂培养基;英文名称:Sulfite Cycloserine Agar Base;产品别名:SC琼脂培养基基础;SC琼脂培养基;使用说明:称取本品40克,加热溶解于1000ml蒸馏水中,121℃高压灭菌15分钟,冷却至44-47℃时,加入10ml过滤除菌的4%D-环丝安酸溶夜,混匀,倾入无菌平皿,备用;产品规格:250g/瓶;产品用途:用于产气荚膜梭菌的计数和培养,需添加D-环丝安酸溶夜及50%卵黄盐水悬夜
可溶性淀粉琼脂培养基;英文名称:Soluble Starch Agar;产品别名:可溶性淀粉琼脂培养基基础;可溶性淀粉琼脂培养基;使用说明:称取本品30.0g于1L蒸馏水或去离子水中,121℃高压灭菌15分钟,灭菌结束后请摇匀,以防琼脂沉积于器皿底部而凝固,备用。本品含有大量不溶物;产品规格:250g/瓶;产品用途:用于细菌淀粉水解试验
酵母浸出粉胨葡萄糖琼脂培养基;英文名称:Yeast Extract Peptone Dextrose Agar;产品别名:酵母浸出粉胨葡萄糖琼脂培养基基础;YPD培养基;酵母浸出粉胨葡萄糖琼脂培养基(YPD);使用说明:称取本品49.0g于1L蒸馏水或去离子水中,加热至完全溶解,分装,115℃高压灭菌30分钟,灭菌结束后请摇匀,以防琼脂沉积于器皿底部而凝固,备用;产品规格:250g/瓶;产品用途:用于真菌计数
抗生素培养基G[PH7.0];英文名称:Medium G(PH7.0);产品别名:抗生素培养基基础G[PH7.0];抗生素培养基G[PH7.0];使用说明:NULL;产品规格:250g/瓶;产品用途:用于抗生素检验,每100ml需添加1支
乳酸菌Cl霉素琼脂培养基2;英文名称:Lactobacillus Chloramphenicol Agar 2;产品别名:乳酸菌Cl霉素琼脂培养基基础2;乳酸菌Cl霉素琼脂培养基2;使用说明:NULL;产品规格:500g/瓶;产品用途:用于干酪乳杆菌和乳酸片球菌的培养
AC肉汤培养基;英文名称:AC Broth;产品别名:AC肉汤培养基基础;AC肉汤培养基;使用说明:称取本品34.2g,加热煮沸溶解于1000ml蒸馏水中,分装,121℃高压灭菌15分钟,备用;产品规格:250g/瓶;产品用途:用于常见微生物的培养和不含防腐剂的样品的检测
胰蛋白胨大豆肉汤培养基;英文名称:Trypticase Soy Broth;产品别名:胰蛋白胨大豆肉汤培养基基础;TSB培养基;胰蛋白胨大豆肉汤培养基(TSB);使用说明:称取本品30.0g于1L蒸馏水或去离子水中,微温溶解,分装,121℃高压灭菌15分钟,备用。配制双料胰蛋白胨大豆肉汤时,除蒸馏水外,其它成分加倍。如制备改良胰蛋白胨大豆肉汤培养基(mTSB),培养基灭菌后冷至50℃以下,无菌操作,每225ml添加2.25mg多粘菌素B、2.25mg萘啶酮酸各1支,混匀,分装,备用;产品规格:250g/瓶;产品用途:用于细菌的增菌和培养
小牛浸夜肉汤培养基;英文名称:Veal Infusion Broth;产品别名:小牛浸夜肉汤培养基基础;小牛浸夜肉汤培养基;使用说明:NULL;产品规格:250g/瓶;产品用途:用于苛养菌的培养
酵母培养基[无维生素];英文名称:Vitamin Free Yeast Base;产品别名:酵母培养基基础[无维生素];酵母培养基[无维生素];使用说明:称取本品16.8溶于100ml蒸馏水或去离子水中,选择性加入维生素,微温溶解,过滤除菌,制成10倍浓缩夜,2~8℃保存。无菌环境下,使用无菌移夜器移0.5ml上述浓缩夜于4.5ml无菌蒸馏水中,备用;产品规格:250g/瓶;产品用途:用于通过维生素的利用对酵母菌进行分类
产芽孢肉汤培养基;英文名称:Sporulation Broth;产品别名:产芽孢肉汤培养基基础;产芽孢肉汤培养基;使用说明:称取本品33.0g,加热溶解于1000ml蒸馏水中,分装试管,每管15ml,121℃高压灭菌15分钟,备用;产品规格:250g/瓶;产品用途:用于产气荚膜梭菌的芽孢试验
MSE琼脂培养基;英文名称:MSE Agar;产品别名:MSE琼脂培养基基础;MSE琼脂培养基;使用说明:称取本品136.6g于1L蒸馏水或去离子水中(可按比例增加或减少配制量),加热煮沸至完全溶解,分装,110℃高压灭菌20分钟,灭菌结束后请摇匀,以防琼脂沉积于器皿底部而凝固,备用;产品规格:250g/瓶;产品用途:用于奶、奶制品和甜食中明珠串球菌的计数
APA培养基;英文名称:APA Medium Base;产品别名:APA培养基基础;APA培养基;使用说明:称取本品64.0g于900ml蒸馏水或去离子水中,煮沸溶解1分钟,补水至1000ml,分装,121℃灭菌15分钟,冷至55℃左右,加入10%无菌碳酸钠溶夜100ml,混匀,调节pH9.8±0.2(25℃),备用;产品规格:250g/瓶;产品用途:用于嗜盐菌的培养,灭菌后需添加1%无菌碳酸钠
放线菌肉汤粉末培养基
幽门螺杆菌琼脂培养基;英文名称:Helicobacter pylori Agar Medium Base;产品别名:幽门螺杆菌琼脂培养基基础;幽门螺杆菌琼脂培养基;使用说明:称取本品4.25g于93ml蒸馏水或去离子水中,加热煮沸至完全溶解,分装,121℃高压灭菌15分钟,灭菌结束后请摇匀,冷至50℃左右,每93ml加入7ml无菌裂解马血以及1支幽门螺杆菌选择性添加剂,混匀,倾注平板;产品规格:250g/瓶;产品用途:用于幽门螺杆菌的分离培养,每100ml添加1支幽门螺杆菌选择性添加剂和7ml无菌裂解马血
改良亮绿琼脂培养基;英文名称:Brilliant Green Agar Modified;产品别名:改良亮绿琼脂培养基基础;改良亮绿琼脂培养基;使用说明:NULL;产品规格:250g/瓶;产品用途:用于沙门氏菌选择性分离
TGC流体培养基;英文名称:TGC Medium ,Fluid;产品别名:TGC流体培养基基础;TGC流体培养基;使用说明:称取本品29.3g于1L蒸馏水或去离子水中,煮沸溶解,分装,121℃高压灭菌15分钟,灭菌后迅速冷却;产品规格:250g/瓶;产品用途:用于无菌检验
硫酸盐还原菌培养基B;英文名称:Postgate’s Medium B for Sulfate Reducers;产品别名:硫酸盐还原菌培养基基础B;硫酸盐还原菌培养基B;使用说明:称取本品6.2g于1L去离子水中,(如培养海洋微生物,则需要添加适量Cl化钠或使用海水代替去离子水配制培养基),煮沸溶解,分装,每100ml添加1支35%乳酸钠溶夜,121℃高压灭菌15分钟,冷却,备用;产品规格:250g/瓶;产品用途:用于脱硫微生物的分离与培养,每100ml添加1支35%乳酸钠溶夜
Eugon LT 100琼脂培养基;英文名称:Eugon LT 100 Agar Base;产品别名:Eugon LT 100琼脂培养基基础;Eugon LT 100琼脂培养基;使用说明:称取本品47.4g于1L蒸馏水或去离子水中,加热煮沸至完全溶解,分装,每200ml添加1支1ml吐温80,121℃高压灭菌15分钟,灭菌结束后请摇匀,倾注平板,备用。本品因含有辛苯聚醇-9而略潮湿,易结块,但不影响产品品质;产品规格:250g/瓶;产品用途:用于化妆品中细菌总数的测定,每200ml添加1支吐温80
BG 11琼脂培养基;英文名称:Medium BG 11 for Cyanobacteria;产品别名:BG 11琼脂培养基基础;BG 11琼脂培养基;使用说明:称取本品11.69g于1L蒸馏水或去离子水中,加热煮沸1分钟使彻底溶解,分装,121℃高压灭菌15分钟,冷却,备用;产品规格:500g/瓶;产品用途:用于蓝细菌的培养
幽门螺杆菌琼脂培养基;英文名称:Helicobacter pylori Agar Medium Base;产品别名:幽门螺杆菌琼脂培养基基础;幽门螺杆菌琼脂培养基;使用说明:称取本品4.25g于93ml蒸馏水或去离子水中,加热煮沸至完全溶解,分装,121℃高压灭菌15分钟,灭菌结束后请摇匀,冷至50℃左右,每93ml加入7ml无菌裂解马血以及1支幽门螺杆菌选择性添加剂,混匀,倾注平板;产品规格:250g/瓶;产品用途:用于幽门螺杆菌的分离培养,每100ml添加1支幽门螺杆菌选择性添加剂和7ml无菌裂解马血
"

![放线菌肉汤培养基[源头供货]](https://img.chemicalbook.com/SupplyImg1/2025-01-22/Large/202501222043051627275.jpg)